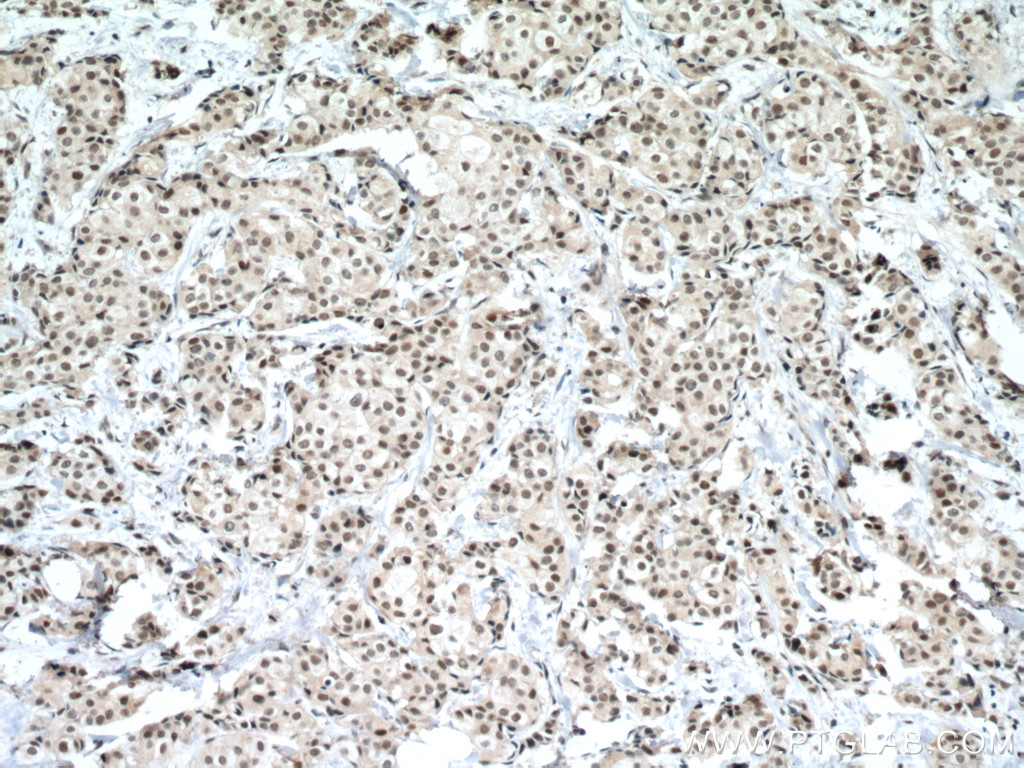
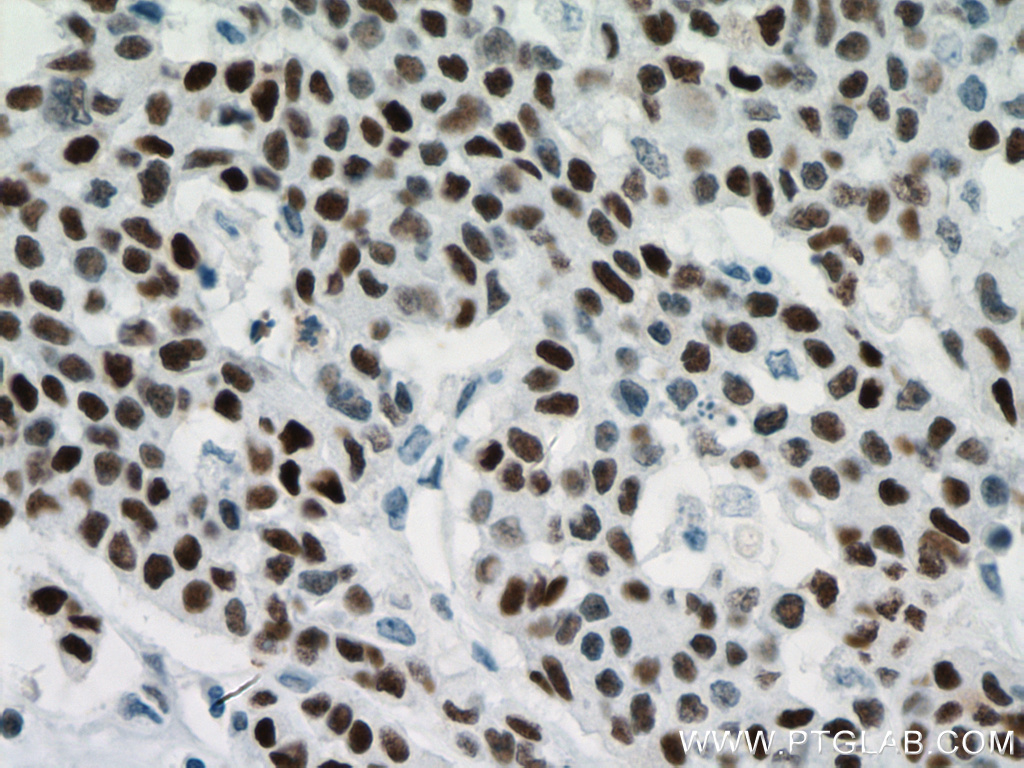

验证数据展示
经过测试的应用
| Positive WB detected in | A431 cells, COLO 320 cells, HSC-T6 cells, rat thymus tissue, ROS1728 cells, HaCaT cells, HT-29 cells, HEK-293 cells |
| Positive IHC detected in | human ovary cancer tissue, human breast cancer tissue, human colon cancer tissue, human gliomas tissue, human lung cancer tissue, human ovary tumor tissue, human stomach cancer tissue, human tonsillitis tissue Note: suggested antigen retrieval with TE buffer pH 9.0; (*) Alternatively, antigen retrieval may be performed with citrate buffer pH 6.0 |
| Positive IF/ICC detected in | A431 cells |
| Positive ChIP-qPCR detected in | HCT 116 cells |
推荐稀释比
| 应用 | 推荐稀释比 |
|---|---|
| Western Blot (WB) | WB : 1:5000-1:50000 |
| Immunohistochemistry (IHC) | IHC : 1:2000-1:8000 |
| Immunofluorescence (IF)/ICC | IF/ICC : 1:400-1:1600 |
| CHIP-QPCR | CHIP-QPCR : 1:10-1:100 |
| It is recommended that this reagent should be titrated in each testing system to obtain optimal results. | |
| Sample-dependent, Check data in validation data gallery. | |
产品信息
60283-2-Ig targets P53 in WB, IHC, IF/ICC, IP, CoIP, ELISA, ChIP-qPCR applications and shows reactivity with human, rat samples.
| 经测试应用 | WB, IHC, IF/ICC, ELISA, ChIP-qPCR Application Description |
| 文献引用应用 | WB, IHC, IF, IP, CoIP |
| 经测试反应性 | human, rat |
| 文献引用反应性 | human, rat, pig, rabbit, canine, zebrafish, bovine, hamster |
| 免疫原 |
CatNo: Ag0698 Product name: Recombinant human P53 protein Source: e coli.-derived, PGEX-4T Tag: GST Domain: 1-232 aa of BC003596 Sequence: MEEPQSDPSVEPPLSQETFSDLWKLLPENNVLSPLPSQAMDDLMLSPDDIEQWFTEDPGPDEAPRMPEAAPRVAPAPAAPTPAAPAPAPSWPLSSSVPSQKTYQGSYGFRLGFLHSGTAKSVTCTYSPALNKMFCQLAKTCPVQLWVDSTPPPGTRVRAMAIYKQSQHMTEVVRRCPHHERCSDSDGLAPPQHLIRVEGNLRVEYLDDRNTFRHSVVVPYEPPEVGSDCTTI 种属同源性预测 |
| 宿主/亚型 | Mouse / IgG2b |
| 抗体类别 | Monoclonal |
| 产品类型 | Antibody |
| 全称 | tumor protein p53 |
| 别名 | TP53, 6C4B6, Antigen NY-CO-13, tumor protein p53, Tumor suppressor p53 |
| 计算分子量 | 44 kDa |
| 观测分子量 | 53 kDa |
| GenBank蛋白编号 | BC003596 |
| 基因名称 | P53 |
| Gene ID (NCBI) | 7157 |
| RRID | AB_2881401 |
| 偶联类型 | Unconjugated |
| 形式 | Liquid |
| 纯化方式 | Protein A purification |
| UNIPROT ID | P04637 |
| 储存缓冲液 | PBS with 0.02% sodium azide and 50% glycerol, pH 7.3. |
| 储存条件 | Store at -20°C. Stable for one year after shipment. Aliquoting is unnecessary for -20oC storage. |
背景介绍
1. What is p53?
P53 is a tumor suppressor gene that plays a role in maintaining genomic stability and controlling apoptosis. During the cell cycle, it can arrest cells at the G1/S checkpoint and activate DNA repair mechanisms. It is the most mutated gene in cancer. In unstressed cells, p53 usually exists at low levels in an inactive form, being bound to Mdm2.
2. FAQs and p53
a. I fail to detect p53 by western blotting
Basal levels of wild-type p53 in untreated cells can be low. Try to load more cell lysate and use a positive control - a lysate of cells treated with DNA-damaging agents should increase p53 levels.
b. I fail to detect p53 in some cell lines by western blotting
Various p53 mutations are present in cancer cell types. If mutations cause truncations/deletions some monoclonal antibodies may no longer recognize mutated p53. You have more chances of detecting various p53 mutants with our polyclonal antibody.
c. I can detect more than one band ~50 kDa size / different cell lines give bands at slightly different size
p53 is a subject of post-translational modifications (http://p53.free.fr/p53_info/p53_modifications.html) and more than one isoform may be expressed (http://p53.free.fr/p53_info/p53_isoforms.html). Also, it is possible that your cell line of interest expresses one allele with mutated p53 with altered molecular weight.
实验方案
| Product Specific Protocols | |
|---|---|
| IF protocol for P53 antibody 60283-2-Ig | Download protocol |
| IHC protocol for P53 antibody 60283-2-Ig | Download protocol |
| WB protocol for P53 antibody 60283-2-Ig | Download protocol |
| Standard Protocols | |
|---|---|
| Click here to view our Standard Protocols |
发表文章
| Species | Application | Title |
|---|---|---|
Bioact Mater Chemo-immunotherapy by dual-enzyme responsive peptide self-assembling abolish melanoma | ||
Redox Biol Deficiency of S100 calcium binding protein A9 attenuates vascular dysfunction in aged mice | ||
Aging (Albany NY) Whole-transcriptome sequencing analysis reveal mechanisms of Yiqi Huoxue Yangyin (YHY) decoction in ameliorating D-gal-induced cardiac aging | ||
J Adv Res TRPM2-mediated feed-forward loop promotes chondrocyte damage in osteoarthritis via calcium-cGAS-STING-NF-κB pathway | ||
Clin Transl Med p53 inhibits OTUD5 transcription to promote GPX4 degradation and induce ferroptosis in gastric cancer |